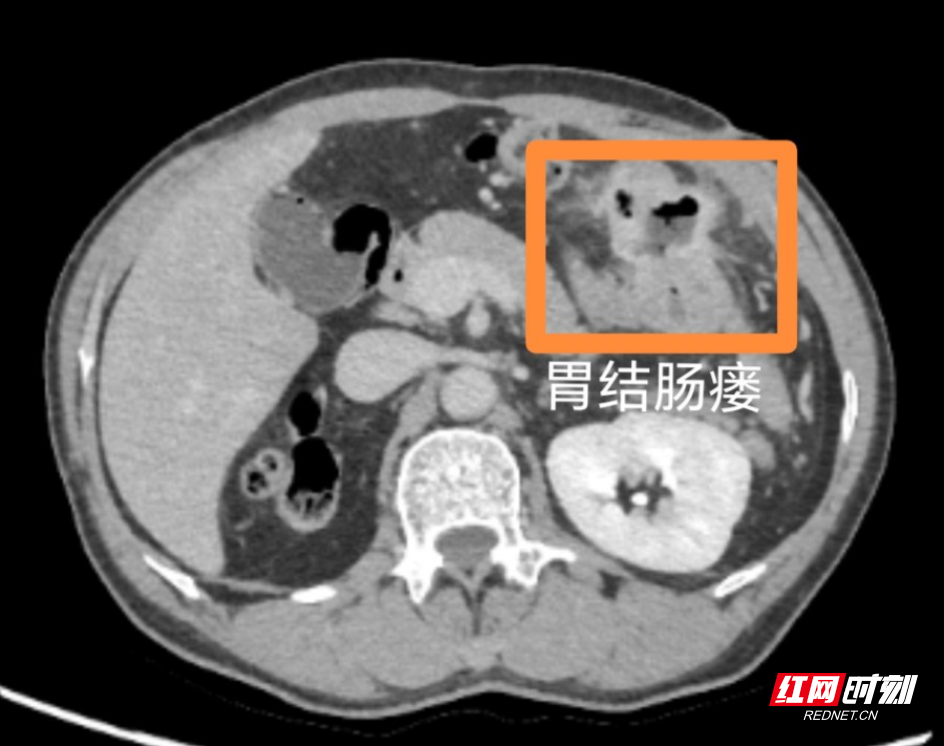
图片 1.jpg

红网时刻新闻4月16日郴州讯(通讯员 李冬艳 庞艳)近日,郴州市第四人民医院普外科团队成功为一名罕见胃结肠瘘合并严重腹腔粘连患者实施腹腔镜下微创手术,完整切除瘘管并完成消化道重建。患者术后恢复顺利,体重回升,目前已康复出院。
患者何先生,今年56岁,5个月前出现持续性腹泻,每日平均排便6次,粪便中可见未消化食物残渣,并伴有腹痛、腹胀的症状,患者体重下降明显,5个月内体重减轻了6公斤。患者自行服用了止泻类药物,但无明显效果,症状持续加重后,辗转至我院就诊。

入院后,经胃镜、肠镜、腹部CT等检查,患者被确诊为胃结肠瘘。因胃与结肠之间形成异常通道,食物未经充分消化直接进入大肠,导致严重营养不良。然而,患者既往有胃大部切除术(毕II式吻合)、肾切除术病史,腹腔正常解剖结构已被破坏,加之长期感染与手术影响,腹腔脏器粘连极为严重,局部组织水肿脆弱,手术风险高、操作难度大。
为保障手术安全与疗效,普外科团队多次开展术前讨论,制定周密手术方案,最终选择采用腹腔镜微创手术方式开展治疗。

术中,观察到腹腔内组织(尤其是腹膜、肠管壁及系膜等)出现广泛粘连、僵硬,如同被冻结一样,失去正常柔软。术中,专家团队在“无间隙”的腹腔内精细分离粘连组织、精准切除瘘管,顺利完成消化道重建。手术历时 6 小时,术中出血极少,未发生副损伤。
术后,在医护团队精心治疗和护理下,患者胃肠功能逐步恢复,可正常进食,腹泻、腹痛等症状消失,体重稳步回升,顺利康复出院。
此次疑难病例的成功救治,充分展现了医院普外科的技术实力与综合诊疗能力。未来,郴州市第四人民医院将继续深耕疑难重症救治领域,不断提升医疗技术水平,为广大患者提供更优质、高效的医疗服务。
来源:红网时刻
作者:李冬艳 庞艳
编辑:何雨杏
本文为郴州站原创文章,转载请附上原文出处链接和本声明。